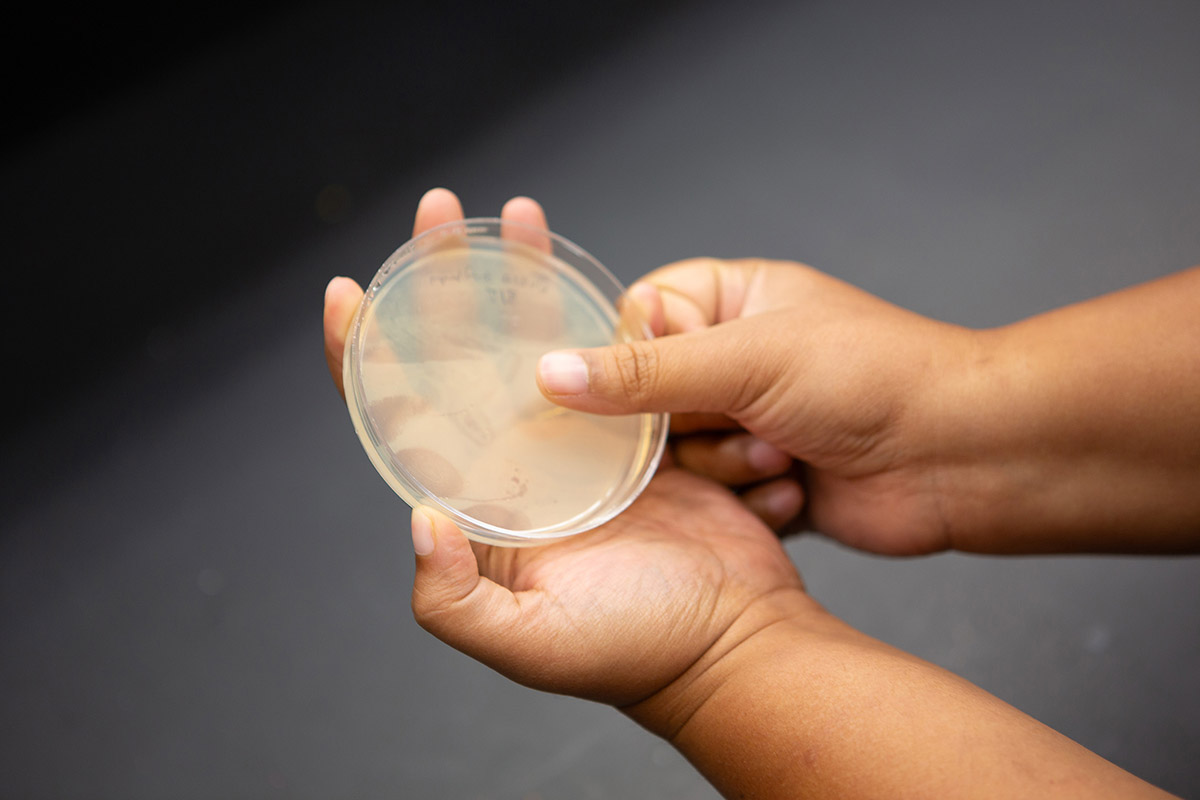
Science imagery

CURATED BY
Julia Pollack
WHEN
December 5 - December 5
WHERE
Cafeteria & Company
View Gallery
1
/
10

Cancer has affected humanity since time immemorial, with the earliest record appearing in ancient Egyptian manuscripts. The inherent nature of the disease is inconsistent, challenging researchers across the globe: It can manifest in different types of cells, either remaining stationary in one part of the body and serving as an easy target or spreading across the body with heartbreaking consequences. And yet, there is hope. Every year new and innovative therapeutics are created by scientists who are as stubborn as the disease, bringing us closer to the possibility that cancer will become a distant memory.

The artist created this piece by superimposing colorectal cancer cells on images of chrysanthemum flowers. Many of us tend to think of cancer cells as solid tumors that either lodge themselves in one place or are passively carried to another part of the body. However, cancer cells, just like flowers, are dynamic. They respond to cellular forces all around them, constantly reorganizing their processes based on their environmental cues. Much like an early spring bud which has to listen to the world around it before it decides to effloresce.



Throughout our lives we are told to not judge a book by its cover; internal beauty is more important than external appearances. And yet, that doesn’t stop us from wishing we could peek into things – whether it is a fruit to decide if it is ripe enough, or the minds of people to understand what they really think, or even our own bodies to figure out if the pain is a passing moment or if it is a serious symptom of an underlying disease.
Although such hypotheticals are not yet possible on a macro scale, it is possible to catch a quick glimpse on a micro scale. An example includes microscopy techniques that can decipher cellular structures, like a nucleus, without breaking open a cell. Using such methods, researchers can visualize embryo development without harming the life inside. The artist juxtaposed images of mice embryos with fruit because of the striking commonality: both have life hidden inside, waiting to burst forth.



Throughout our lives we are told to not judge a book by its cover; internal beauty is more important than external appearances. And yet, that doesn’t stop us from wishing we could peek into things – whether it is a fruit to decide if it is ripe enough, or the minds of people to understand what they really think, or even our own bodies to figure out if the pain is a passing moment or if it is a serious symptom of an underlying disease.
Although such hypotheticals are not yet possible on a macro scale, it is possible to catch a quick glimpse on a micro scale. An example includes microscopy techniques that can decipher cellular structures, like a nucleus, without breaking open a cell. Using such methods, researchers can visualize embryo development without harming the life inside. The artist juxtaposed images of mice embryos with fruit because of the striking commonality: both have life hidden inside, waiting to burst forth.



The word “root” has countless meanings: it is a place where something can spring into being, it can be a mathematical concept or a linguistic one, it can refer to a part of a tooth, or it can be as simple as a plant organ that is hidden underground. Plant roots serve as anchors – they hold the body in place while making sure it absorbs enough water and dissolved minerals from the soil. However, even these sturdy structures are vulnerable to the vagaries of climate change.
Plants have several defenses in response to flooding events, which cause over 15% of global crop losses. These adaptations can include increasing the number of roots, changing the root structure, or using the air channels inside the roots to breathe. Through this root portrait, the artist wanted to highlight these hidden heroes that play such a vital role in plant growth. The image reminds us that even an understated arrangement can birth a galaxy of wonderful possibilities.



For over four centuries, biologists have been trying to understand what lies within a cell. First they tried to observe living organisms that were about 100 times smaller than the diameter of human hair. Then they wanted to break open these cells to see what their genetic material looks like, which is approximately 1000 times smaller than the cells. By observing these genetic structures, scientists can visualize how abnormalities on a nanoscale can affect the organism as a whole, whether it is a microscopic bacteria or a human.
The original images have been taken using the MINFLUX microscope housed at the Carl R. Woese Institute of Genomic Biology. The microscope is unique because instead of imaging a static structure it helps researchers track the dynamic interactions of molecules inside a cell. Inspired by the electric boogaloo, a freestyle street dance movement characterized by illusions, unusual shapes, and wiggling, the artist used patterns from other MINFLUX images to create an energetic rendering of what DNA looks like; it can be free flowing individual pieces or it can join together in a chromosome, like a circle dance.


Thoughts from the researcher:
The MINFLUX scope is unique because it allows researchers to visualize structures in unprecedented detail. The image depicts a specific isolated chromosome stained for chromosome axis proteins, SYCP3 and SYCP1, using MINFLUX. The importance of this image lies in its ability to shed light on underlying mechanisms of chromosomal abnormalities that can lead to infertility and birth defects. By using MINFLUX to measure the widths of SYCP3 in wild-type and mutant germline cells, researchers are able to confirm the presence of a bilayer structure of chromosome axes in germline cells. This knowledge can ultimately help in developing treatments in order to improve the quality of life.

For over four centuries, biologists have been trying to understand what lies within a cell. First they tried to observe living organisms that were about 100 times smaller than the diameter of human hair. Then they wanted to break open these cells to see what their genetic material looks like, which is approximately 1000 times smaller than the cells. By observing these genetic structures, scientists can visualize how abnormalities on a nanoscale can affect the organism as a whole, whether it is a microscopic bacteria or a human.
The original images have been taken using the MINFLUX microscope housed at the Carl R. Woese Institute of Genomic Biology. The microscope is unique because instead of imaging a static structure it helps researchers track the dynamic interactions of molecules inside a cell. Inspired by the electric boogaloo, a freestyle street dance movement characterized by illusions, unusual shapes, and wiggling, the artist used patterns from other MINFLUX images to create an energetic rendering of what DNA looks like; it can be free flowing individual pieces or it can join together in a chromosome, like a circle dance.



Imagine stepping into a time machine and going back to 300 million years ago. You walk out and a warm, moist breeze greets you. It is not the humidity from corn sweat; it’s from entering a vast coastal swamp forest. Illinois used to be located near the equator as part of the supercontinent Pangaea. Over the next few millennia, the area turned into a warm, dry landscape of hills and valleys and was subsequently flattened by glaciers that formed during the Ice Age. We can only imagine what this land will look like several million years from now.



Our understanding of Illinois’ flora stems, in part comes from coal balls – fossils that are formed when minerals from water fill in the open spaces of an organism. These petrified plant fossils allow us to understand the ecology and biodiversity of our past. Inspired by the history of Illinois, the artist used watercolors to bestow the feel of an old photograph on the research image. The subtle grid is a nod to how the specimens are analyzed square by square. When we think of mass extinctions, we usually think of animals disappearing, but if you look at the piece closely, you will see the extinct plants, which are too often forgotten when we look back at the history of our planet.





Balance is essential to the Earth. Elements like carbon and nitrogen are constantly moving in a giant circle from the air, into the bodies of plants and animals, and eventually back into the air. These cycles depend on tiny but vital players: microbes. In the carbon cycle, they feed on decaying plant and animal matter to release carbon dioxide, which is taken up by plants to ultimately feed the entire food chain. In the nitrogen cycle, only microbes can convert nitrogen gas into a form that can be used by plants, again benefitting all life on Earth. Without microbes, life as we know it would cease to exist.

This piece was created using Winogradsky columns, simple experiments that illustrate the diversity of microbial life and their ability to cycle different elements. The column can essentially be made with just pond water and mud, and over time bacteria separate out into layers based on their place in the chemical cycles. The artist has used one-year-old columns to make a Rothkoesque piece, which is characterized by rectangular regions of color. These columns can last for many years, which is perhaps unsurprising since bacteria have been fulfilling their roles in the chemical cycles for billions of years.





“No man is an island,
Entire of itself,
Every man is a piece of the continent, A part of the main.”
When the English poet John Donne penned these words 400 years ago, little did he realize how true it would ring in the context of microbiology. We are surrounded by microbes. When we brush past strangers, share a hug with a friend, or even give our loved ones a kiss, we share millions of our microbial friends with each other.

This piece was created through a collaboration of the artist and the writer imprinting their microbial communities on LB plates: a nutritious jelly that is designed to help bacteria grow. At first they used separate plates, as seen on the left. Upon introspection, they also created one where their microbes had a chance to grow together, as seen in the middle plate on the right. Using geometric patterns, the piece poses the question: are we really a hyper individualistic society that takes advantage of the world around us, or are we all mere passengers making our way through a microbial world that binds us all together with a multitude of invisible connections?

“No man is an island,
Entire of itself,
Every man is a piece of the continent, A part of the main.”
When the English poet John Donne penned these words 400 years ago, little did he realize how true it would ring in the context of microbiology. We are surrounded by microbes. When we brush past strangers, share a hug with a friend, or even give our loved ones a kiss, we share millions of our microbial friends with each other.
This piece was created through a collaboration of the artist and the writer imprinting their microbial communities on LB plates: a nutritious jelly that is designed to help bacteria grow. At first they used separate plates, as seen on the left. Upon introspection, they also created one where their microbes had a chance to grow together, as seen in the middle plate on the right. Using geometric patterns, the piece poses the question: are we really a hyper individualistic society that takes advantage of the world around us, or are we all mere passengers making our way through a microbial world that binds us all together with a multitude of invisible connections?


On a hot summer day, as you drive north from Urbana-Champaign you might notice the sea of green on either side of the highway. Although these waves of corn and soybean are a breathtaking sight, they also remind us of how much is at stake in the face of rising temperatures and severe droughts. Researchers are, therefore, diligently working to engineer crops that can withstand these challenges so that all of us will continue to have access to enough food in the face of global warming.
The original research image was one of the first 3D reconstructions of the cell structures in corn and sugarcane. Inspired by Elsworth Kelly’s work, the artist placed those structures against the silhouettes of the plants. Through these minimalist contour drawings, she invites us to connect the internal workings of a plant, which can only be seen through a microscope, to its external form. By doing so, we can understand the sheer scale of moving parts that can be tinkered with to achieve global food sustainability.


On a hot summer day, as you drive north from Urbana-Champaign you might notice the sea of green on either side of the highway. Although these waves of corn and soybean are a breathtaking sight, they also remind us of how much is at stake in the face of rising temperatures and severe droughts. Researchers are, therefore, diligently working to engineer crops that can withstand these challenges so that all of us will continue to have access to enough food in the face of global warming.
The original research image was one of the first 3D reconstructions of the cell structures in corn and sugarcane. Inspired by Elsworth Kelly’s work, the artist placed those structures against the silhouettes of the plants. Through these minimalist contour drawings, she invites us to connect the internal workings of a plant, which can only be seen through a microscope, to its external form. By doing so, we can understand the sheer scale of moving parts that can be tinkered with to achieve global food sustainability.


On a hot summer day, as you drive north from Urbana-Champaign you might notice the sea of green on either side of the highway. Although these waves of corn and soybean are a breathtaking sight, they also remind us of how much is at stake in the face of rising temperatures and severe droughts. Researchers are, therefore, diligently working to engineer crops that can withstand these challenges so that all of us will continue to have access to enough food in the face of global warming.
The original research image was one of the first 3D reconstructions of the cell structures in corn and sugarcane. Inspired by Elsworth Kelly’s work, the artist placed those structures against the silhouettes of the plants. Through these minimalist contour drawings, she invites us to connect the internal workings of a plant, which can only be seen through a microscope, to its external form. By doing so, we can understand the sheer scale of moving parts that can be tinkered with to achieve global food sustainability.


Every year, many of us make a beeline to the nearest flu vaccine clinic. Although large-scale vaccination efforts for the flu have existed since 1945, every year researchers have to develop new versions of these vaccines. These new formulations are necessary because the influenza virus is continuously evolving, changing how our immune systems see it. Although it is impossible to know when the virus first infected humans, some of the earliest records date back to 6,000 BC. For over eight millenia, our immune systems have been locked in a battle with the influenza virus.
The two images represent the two sides of the story: how our bodies fight the virus, and how researchers work hard to develop new therapies to help us. The artist created the first image by layering her watercolor paintings, which were inspired by the painted ceilings in the Vatican museums that feature the many wars between angels and demons. The second image is based on the researcher’s actual data from mouse lungs that were infected with the influenza virus. Although the battle may seem like a stalemate, the undeterred researchers continue to fight, preventing a million flu-related illnesses every year.


Every year, many of us make a beeline to the nearest flu vaccine clinic. Although large-scale vaccination efforts for the flu have existed since 1945, every year researchers have to develop new versions of these vaccines. These new formulations are necessary because the influenza virus is continuously evolving, changing how our immune systems see it. Although
it is impossible to know when the virus first infected humans, some of the earliest records date back to 6,000 BC. For over eight millenia, our immune systems have been locked in a battle with the influenza virus.
The two images represent the two sides of the story: how our bodies fight the virus, and how researchers work hard to develop new therapies to help us. The artist created the first image by layering her watercolor paintings, which were inspired by the painted ceilings in the Vatican museums that feature the many wars between angels and demons. The second image is based on the researcher’s actual data from mouse lungs that were infected with the influenza virus. Although the battle may seem like a stalemate, the undeterred researchers continue to fight, preventing a million flu-related illnesses every year.


Take a deep breath. Relax your eyes and look at the three panels together. What do you see? Maybe a moth or a bat? Imagine all the colors fading to gray. Do you see something different? Does your perception change if you focus on only one of the panels? To many of us, this piece is reminiscent of Rorschach inkblots that were widely used by psychologists to examine their patient’s personality. Although their use in psychology has all but vanished, they still remain intriguing due to their ability to conjure different interpretations.
The original research image was obtained from a map of genes that are expressed in a honeybee brain, with each color representing a different gene. Honeybees are unique in their ability to make individual decisions that align with the collective mindset of the hive. Through this piece, the artist invites you to do the same: take in the image by yourself and then gather some friends and reexamine the piece. After all, art has a long history of social bonding, whether it is to shape our understanding of the world or enhance the sense of belonging to our own communities.






Most of us have felt the eerie silence before a thunderstorm. A bright day suddenly turns dark and ominous. There’s a certain smell in the air, both comforting and unsettling. And then you hear it. A sudden crack and a torrential downpour, flooding the area, and causing everyone to run for cover. This experience is all too common in the southeast regions of South America, which are home to some of the most intense thunderstorms in the world. In addition to extreme lightning activity and flooding, the storms create hail, which is devastating to the agricultural fields.


The artist has used research images of storms from Argentina and has set them against the background of architectural posters that depict the landscape. By doing so, she has captured the feeling of a devastating storm: It is a giant monster that flattens everything in its path as it advances. The emotional experience has also been incorporated by using images of hail collected from Argentinian Twitter. Taken together, the piece reminds us that our experiences are both unique and universal.





For over 3000 years flags have been used as rallying points, giving people symbols for their causes. Flag design follows the key principles of simplicity and symbolism. The flag should be simple enough that a child can draw it from memory and yet should have an emblem that resonates with the general population.
Using the traditional Korean technique of making patchwork quilts–known as pojagi–the artist created this flag to represent the importance of fighting for our world. The balance of green and blue represent harmony between resources and life. This symmetry is enclosed in a yellow circle that depicts our efforts to deal with climate change. The black background is to remind us that in the vast universe, the Earth is the only home we have and we must protect its magic.

Prompt (optional) Think back to your experiences with climate change. What messages resonate with you? What ideas would you like to convey? What are your hopes and fears for the future generations that will have to deal with climate change? Reflect on these questions as you design your own flag for climate justice.
Scientist Collaborator
Umnia Doha
Md Taher Abu Saif, Saif Group
Instrument
Multiphoton Confocal Microscope Zeiss 710 with Mai Tai eHP Ti:sapphire laser
Funding Agency
Cancer Center at Illinois (CCIL)
Original Imaging


Special Thanks
Kleinmuntz Center for Genomics in Business and Society; Nelson family and BodyWork Associates; Matt Cho and Cafeteria and Company
Image Rights
Images not for public use without permission from the Carl R. Woese Institute for Genomic Biology
Scientist Collaborators
Neha Goswami, Romana A Nowak, Mark A. Anastasio, Gabriel Popescu, and Nichola Winston
QLI Lab, Computational Imaging Science Lab
Instrument
Laser-scanning gradient light interference microscopy and a deep learning from label-free LS-GLIM
Funding Agency
National Institutes of Health
Original Imaging


Special Thanks
Kleinmuntz Center for Genomics in Business and Society; Nelson family and BodyWork Associates; Matt Cho and Cafeteria and Company
Image Rights
Images not for public use without permission from the Carl R. Woese Institute for Genomic Biology
Scientist Collaborators
Neha Goswami, Romana A Nowak, Mark A. Anastasio, Gabriel Popescu, and Nichola Winston
QLI Lab, Computational Imaging Science Lab
Instrument
Laser-scanning gradient light interference microscopy and a deep learning from label-free LS-GLIM
Funding Agency
National Institutes of Health
Original Imaging


Special Thanks
Kleinmuntz Center for Genomics in Business and Society; Nelson family and BodyWork Associates; Matt Cho and Cafeteria and Company
Image Rights
Images not for public use without permission from the Carl R. Woese Institute for Genomic Biology
Scientist Collaborators
Esther Ngumbi, Erinn Dady, and Aaron Mleziva
Esther Ngumbi Group
Instrument
Canon EOS 5
Funding Agency
Startup funds by the University of Illinois Urbana- Champaign
Original Imaging
Special Thanks
Kleinmuntz Center for Genomics in Business and Society; Nelson family and BodyWork Associates; Matt Cho and Cafeteria and Company
Image Rights
Images not for public use without permission from the Carl R. Woese Institute for Genomic Biology
Scientist Collaborators
Reza Rajabi Toustani, Sasha Kakkassery, Kingsley A Boateng, Joe (Huanyu) Qiao
Qiao Group
Instrument
MINFLUX scope
Funding Agency
National Institutes of Health
Original Imaging

Special Thanks
Kleinmuntz Center for Genomics in Business and Society; Nelson family and BodyWork Associates; Matt Cho and Cafeteria and Company
Image Rights
Images not for public use without permission from the Carl R. Woese Institute for Genomic Biology
Scientist Collaborators
Reza Rajabi Toustani, Sasha Kakkassery, Kingsley A Boateng, Joe (Huanyu) Qiao
Qiao Group
Instrument
MINFLUX scope
Funding Agency
National Institutes of Health
Original Imaging


Special Thanks
Kleinmuntz Center for Genomics in Business and Society; Nelson family and BodyWork Associates; Matt Cho and Cafeteria and Company
Image Rights
Images not for public use without permission from the Carl R. Woese Institute for Genomic Biology
Scientist Collaborators
Surangi Punyasena, Scott Lakeram, Scott Elrick
Punyasena Paleoecology Group
Instrument
Zeiss Axio Zoom
Funding Agency
University of Illinois Phillips Fund for Paleobotany (Department of Plant Biology) Illinois State Geological Survey
Original Imaging
Special Thanks
Kleinmuntz Center for Genomics in Business and Society; Nelson family and BodyWork Associates; Matt Cho and Cafeteria and Company
Image Rights
Images not for public use without permission from the Carl R. Woese Institute for Genomic Biology
Scientist Collaborator
Danny Ryerson
IGB Outreach Group
Instrument
Canon EOS 5
Original Imaging
Special Thanks
Kleinmuntz Center for Genomics in Business and Society; Nelson family and BodyWork Associates; Matt Cho and Cafeteria and Company
Image Rights
Images not for public use without permission from the Carl R. Woese Institute for Genomic Biology
Scientist Collaborator
Ananya Sen
IGB Communications Group
Instrument
Canon EOS 5
Original Imaging

Special Thanks
Kleinmuntz Center for Genomics in Business and Society; Nelson family and BodyWork Associates; Matt Cho and Cafeteria and Company
Image Rights
Images not for public use without permission from the Carl R. Woese Institute for Genomic Biology
Scientist Collaborator
Ananya Sen
IGB Communications Group
Instrument
Canon EOS 5
Original Imaging

Special Thanks
Kleinmuntz Center for Genomics in Business and Society; Nelson family and BodyWork Associates; Matt Cho and Cafeteria and Company
Image Rights
Images not for public use without permission from the Carl R. Woese Institute for Genomic Biology
Scientist Collaborators
Moonsub Lee, Donald R. Ort, Ryan A. Boyd, Kingsley A. Boateng
Donald R. Ort Group
Instrument
Serial Block face SEM
Funding Agency
Biological and Environmental Research program, U.S. Department of Energy
Original Imaging


Special Thanks
Kleinmuntz Center for Genomics in Business and Society; Nelson family and BodyWork Associates; Matt Cho and Cafeteria and Company
Image Rights
Images not for public use without permission from the Carl R. Woese Institute for Genomic Biology
Scientist Collaborators
Moonsub Lee, Donald R. Ort, Ryan A. Boyd, Kingsley A. Boateng
Donald R. Ort Group
Instrument
Serial Block face SEM
Funding Agency
Biological and Environmental Research program, U.S. Department of Energy
Original Imaging


Special Thanks
Kleinmuntz Center for Genomics in Business and Society; Nelson family and BodyWork Associates; Matt Cho and Cafeteria and Company
Image Rights
Images not for public use without permission from the Carl R. Woese Institute for Genomic Biology
Scientist Collaborators
Moonsub Lee, Donald R. Ort, Ryan A. Boyd, Kingsley A. Boateng
Donald R. Ort Group
Instrument
Serial Block face SEM
Funding Agency
Biological and Environmental Research program, U.S. Department of Energy
Original Imaging


Special Thanks
Kleinmuntz Center for Genomics in Business and Society; Nelson family and BodyWork Associates; Matt Cho and Cafeteria and Company
Image Rights
Images not for public use without permission from the Carl R. Woese Institute for Genomic Biology
Scientist Collaborators
Elizabeth Rowland, Chris Brooke, and Collin Kieffer
Collin Kieffer Group
Instrument
UltraMicroscope II Lightsheet Microscope with Imaris
Funding Agency
UIUC Microbiology Start-up funds, DARPA
Original Imaging

Special Thanks
Kleinmuntz Center for Genomics in Business and Society; Nelson family and BodyWork Associates; Matt Cho and Cafeteria and Company
Image Rights
Images not for public use without permission from the Carl R. Woese Institute for Genomic Biology
Scientist Collaborators
Elizabeth Rowland, Chris Brooke, and Collin Kieffer
Collin Kieffer Group
Instrument
UltraMicroscope II Lightsheet Microscope with Imaris
Funding Agency
UIUC Microbiology Start-up funds, DARPA
Original Imaging

Special Thanks
Kleinmuntz Center for Genomics in Business and Society; Nelson family and BodyWork Associates; Matt Cho and Cafeteria and Company
Image Rights
Images not for public use without permission from the Carl R. Woese Institute for Genomic Biology
Scientist Collaborators
Alex Schrader, JuYeon Lee, Marisa Asadian, Ian Traniello, Gene E. Robinson and Hee-Sun Han Hee-Sun Han Group
Instrument
Fluorescence Microscope - Zeiss Axiovert 200M with the Apotome
Funding Agency
J&J Cancer Center, European Research Council, Brain2Bee
Original Imaging

Special Thanks
Kleinmuntz Center for Genomics in Business and Society; Nelson family and BodyWork Associates; Matt Cho and Cafeteria and Company
Image Rights
Images not for public use without permission from the Carl R. Woese Institute for Genomic Biology
Scientist Collaborators
Deanna A. Hence, Calvin Elkins, Jeff Trapp, Steve Nesbitt
Deanna A. Hence Group
Funding Agency
National Science Foundation
Original Imaging


Special Thanks
Kleinmuntz Center for Genomics in Business and Society; Nelson family and BodyWork Associates; Matt Cho and Cafeteria and Company
Image Rights
Images not for public use without permission from the Carl R. Woese Institute for Genomic Biology
Scientist Collaborators
Shekhar Mishra, Garima Shukla
Funding Agency
Inspirations and conversations in partnership with Citizen’s Climate Education
Original Imaging

Special Thanks
Kleinmuntz Center for Genomics in Business and Society; Nelson family and BodyWork Associates; Matt Cho and Cafeteria and Company
Image Rights
Images not for public use without permission from the Carl R. Woese Institute for Genomic Biology
Special Thanks
Champaign businessman Doug Nelson, President of BodyWork Associates, first proposed the idea that became Art of Science, and his continued efforts to support the exhibit made its realization possible. The IGB is also grateful to James Barham of Barham Benefit Group and [co][lab] founder Matt Cho for hosting the annual exhibit.